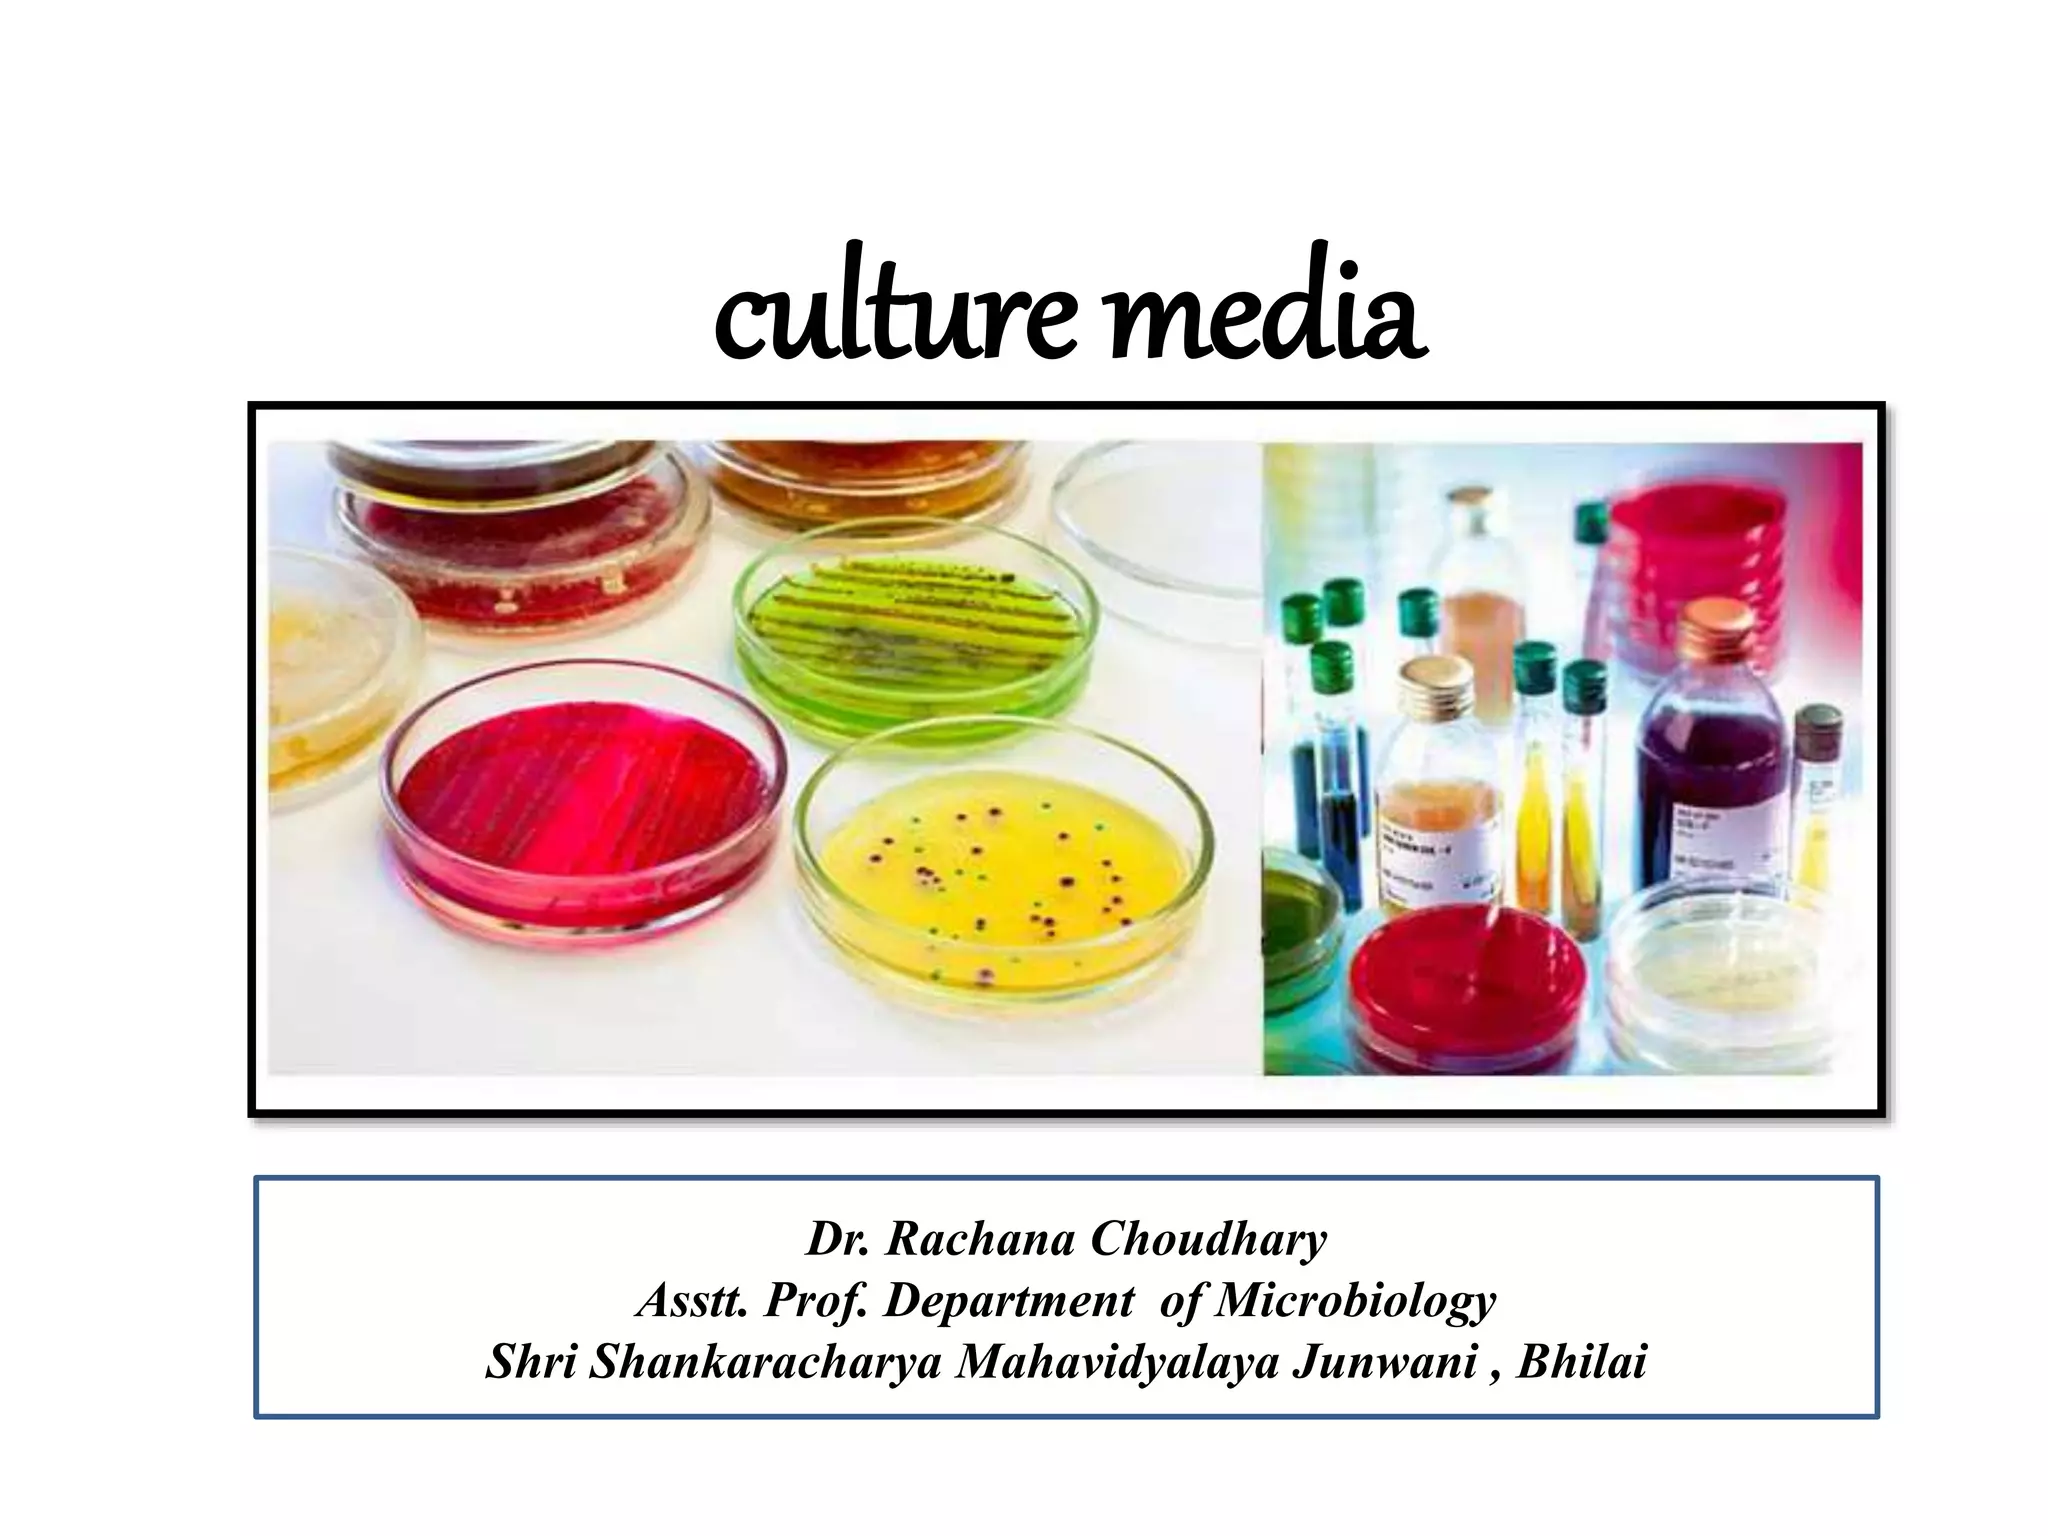
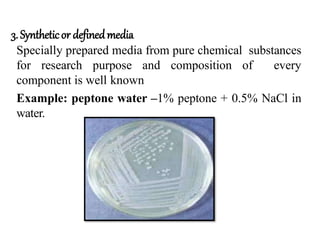
3.Syntheticor definedmedia
Specially prepared media from pure chemical substances
for research purpose and composition of every
component is well known
Example: peptone water –1% peptone + 0.5% NaCl in
water.
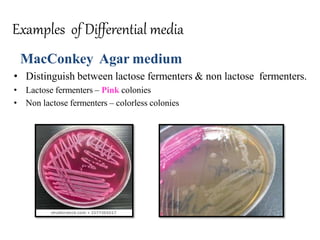
Examples of Differential media
MacConkey Agar medium
• Distinguish between lactose fermenters & non lactose fermenters.
• Lactose fermenters – Pink colonies
• Non lactose fermenters – colorless colonies
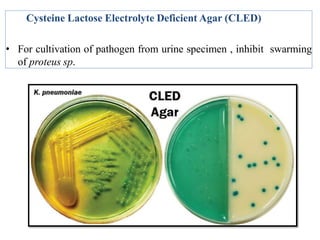
Cysteine Lactose Electrolyte Deficient Agar (CLED)
• For cultivation of pathogen from urine specimen , inhibit swarming
of proteus sp.
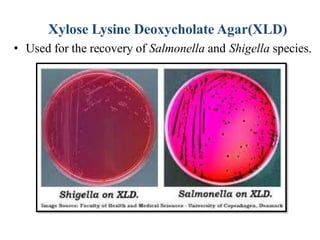
Xylose Lysine Deoxycholate Agar(XLD)
• Used for the recovery of Salmonella and Shigella species.
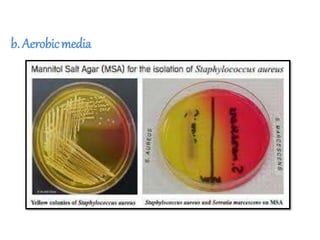
b. Aerobicmedia

The document discusses culture media, which are substances required for growing microorganisms outside the body, with applications for identifying infections, studying microorganisms, and preparing biological products. It categorizes culture media based on physical state (solid, liquid, semi-solid), ingredients (simple, complex, synthetic), and special purposes (enriched, selective, differential, transport). It also emphasizes the importance of proper preparation and sterilization of media for successful microbial growth.